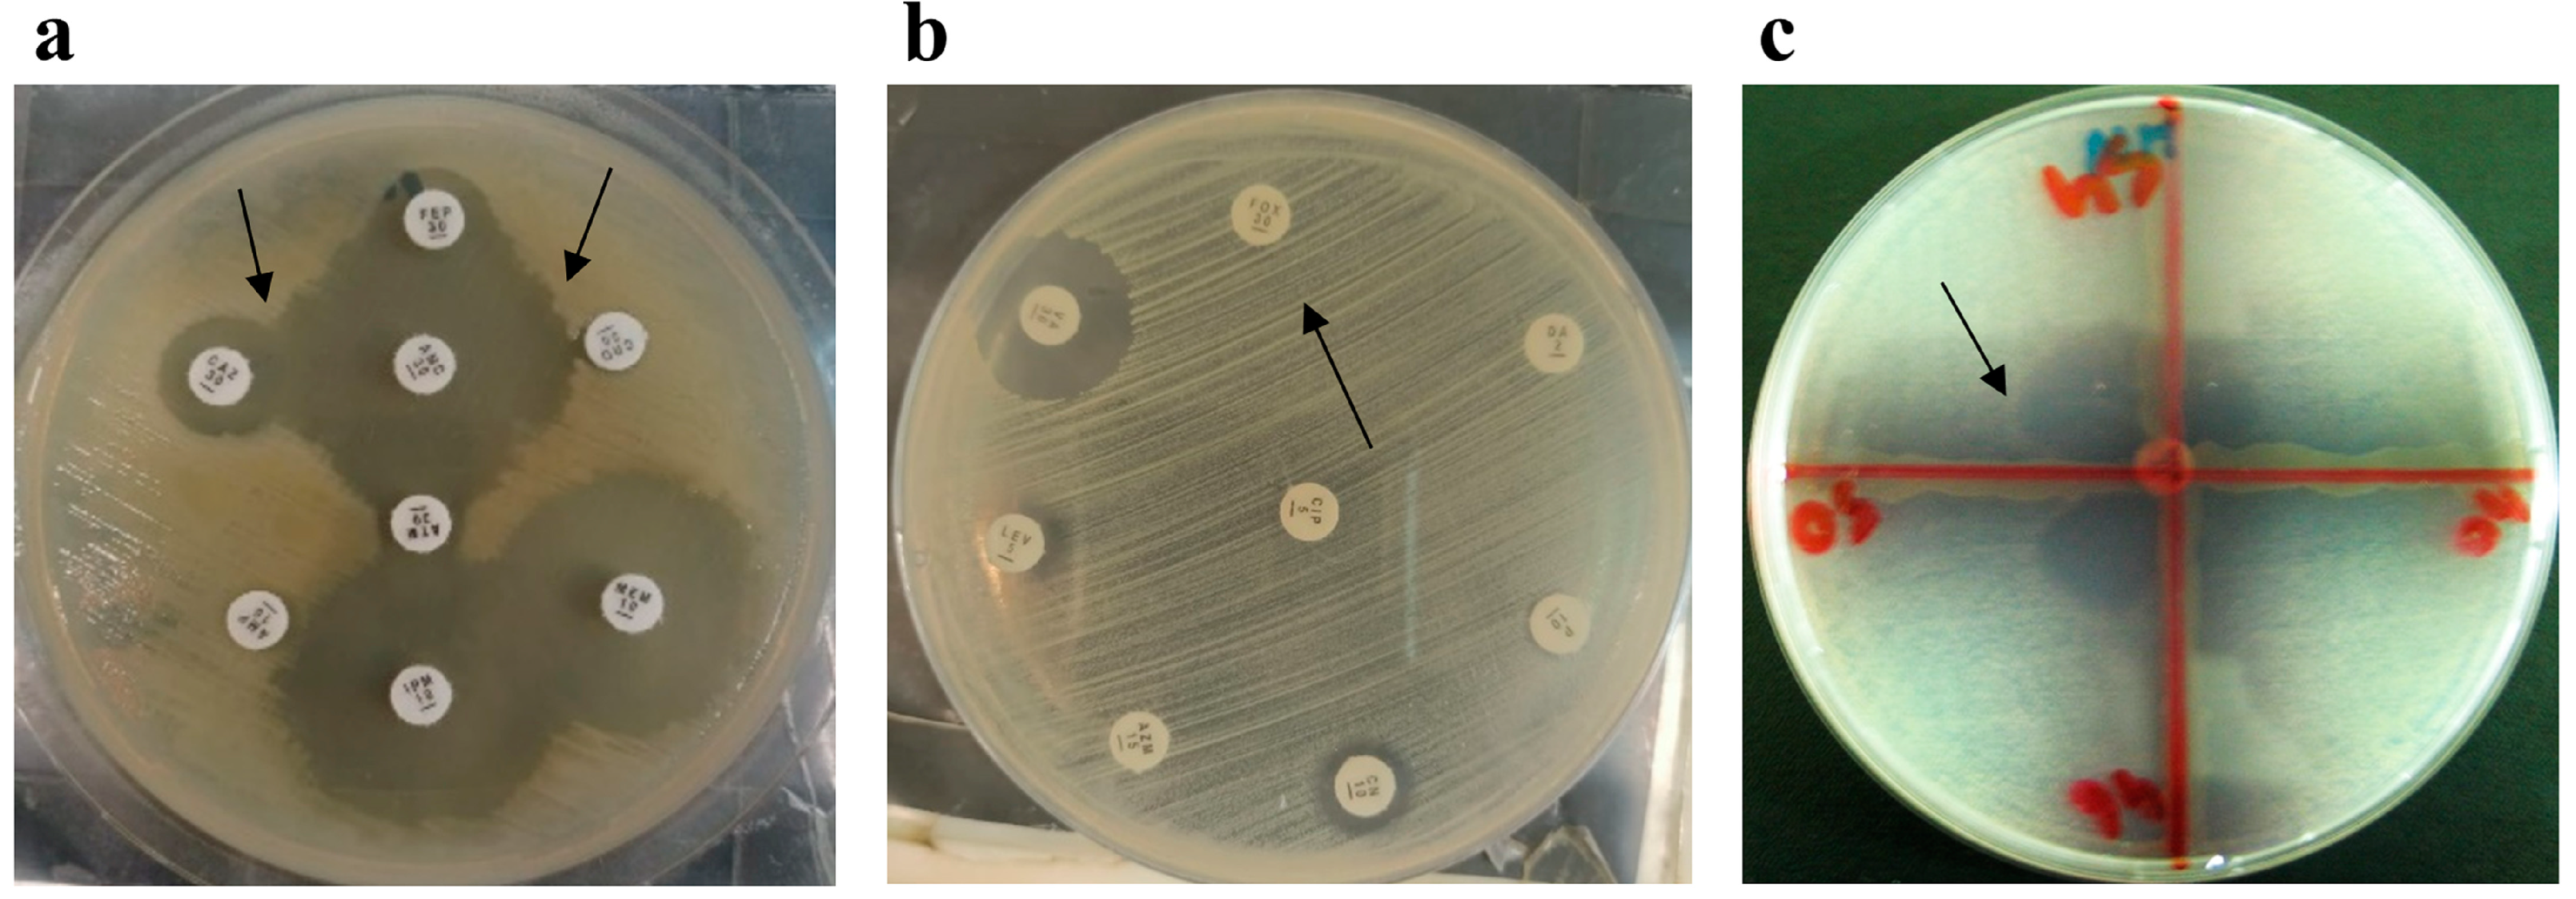

Antibiotic-Resistant Bacteria, Antimicrobial Resistance Genes, and Antibiotic Residue in Food from Animal Sources: One Health Food Safety Concern
Abstract
1. Introduction
2. Materials and Methods
2.1. Study Design
2.2. Sample Collection
2.3. Identification of Bacteria from Food Samples
2.4. Antimicrobial Susceptibility Testing (AST)
2.5. Phenotypic Detection of Methicillin-Resistant Staphylococcus aureus
2.6. Phenotypic Detection of Carbapenemase Production
2.7. Phenotypic Detection of Metallo-β-Lactamases
2.8. Molecular Detection of Antimicrobial Resistance Genes in Food Samples
2.9. Detection of Tetracycline Residue in Beef Samples
2.10. Detection of Tetracycline Residue in Milk Samples
3. Results
3.1. Identification of Isolates from Food Samples
3.2. Minimum Inhibitory Concentration of Antibiotics against Food Pathogens
3.3. Phenotypic Confirmation of Antimicrobial Resistance Genes in Food Samples
3.4. Genotypic Confirmation of Antimicrobial Resistance Genes in Food Samples
3.5. Tetracycline Residues in Bovine Milk and Beef Samples
3.6. Coexistence of Antimicrobial Resistance, Antimicrobial Resistance Genes, and Tetracycline Residues in Bovine Milk and Beef Samples
4. Discussion
5. Conclusions
Author Contributions
Funding
Data Availability Statement
Conflicts of Interest
References
- United Nations. The World Population Prospects 2019: Highlights; United Nations: New York, NY, USA, 2019. Available online: https://population.un.org/wpp/Publications/Files/WPP2019_Highlights.pdf (accessed on 4 January 2023).
- Ghimpețeanu, O.M.; Pogurschi, E.N.; Popa, D.C.; Dragomir, N.; Drăgotoiu, T.; Mihai, O.D.; Petcu, C.D. Antibiotic Use in Livestock and Residues in Food-A Public Health Threat: A Review. Foods 2022, 11, 1430. [Google Scholar] [CrossRef] [PubMed]
- Mitchell, M.E.V.; Alders, R.; Unger, F.; Nguyen-Viet, H.; Le, T.T.H.; Toribio, J.A. The challenges of investigating antimicrobial resistance in Vietnam—What benefits does a One Health approach offer the animal and human health sectors? BMC Public Health 2020, 20, 213. [Google Scholar] [CrossRef] [PubMed]
- Sohaib, M.; Jamil, F. An Insight of Meat Industry in Pakistan with Special Reference to Halal Meat: A Comprehensive Review. Korean J. Food Sci. Anim. Resour. 2017, 37, 329–341. [Google Scholar] [CrossRef]
- Bacanlı, M.; Başaran, N. Importance of antibiotic residues in animal food. Food Chem. Toxicol. Int. J. Publ. Br. Ind. Biol. Res. Assoc. 2019, 125, 462–466. [Google Scholar] [CrossRef] [PubMed]
- Granados-Chinchilla, F.; Rodríguez, C. Tetracyclines in Food and Feedingstuffs: From Regulation to Analytical Methods, Bacterial Resistance, and Environmental and Health Implications. J. Anal. Methods Chem. 2017, 2017, 1315497. [Google Scholar] [CrossRef]
- Brown, K.; Mugoh, M.; Call, D.R.; Omulo, S. Antibiotic residues and antibiotic-resistant bacteria detected in milk marketed for human consumption in Kibera, Nairobi. PLoS ONE 2020, 15, e0233413. [Google Scholar] [CrossRef]
- Kimera, Z.I.; Mdegela, R.H.; Mhaiki, C.J.; Karimuribo, E.D.; Mabiki, F.; Nonga, H.E.; Mwesongo, J. Determination of oxytetracycline residues in cattle meat marketed in the Kilosa district, Tanzania. Onderstepoort J. Vet. Res. 2015, 82, 911. [Google Scholar] [CrossRef] [PubMed]
- Commission Regulation (EU) No 37/2010 of 22 December 2009 on Pharmacologically Active Substances and Their Classification Regarding Maximum Residue Limits in Foodstuffs of Animal Origin. Available online: https://eur-lex.europa.eu/legal-content/EN/TXT/?uri=CELEX%3A32010R0037 (accessed on 22 November 2022).
- El Tahir, Y.; Elshafie, E.I.; Asi, M.N.; Al-Kharousi, K.; Al Toobi, A.G.; Al-Wahaibi, Y.; Al-Marzooqi, W. Detection of Residual Antibiotics and Their Differential Distribution in Broiler Chicken Tissues Using Enzyme-Linked Immunosorbent Assay. Antibiotics 2021, 10, 1305. [Google Scholar] [CrossRef] [PubMed]
- Mdegela, R.H.; Mwakapeje, E.R.; Rubegwa, B.; Gebeyehu, D.T.; Niyigena, S.; Msambichaka, V.; Nonga, H.E.; Antoine-Moussiaux, N.; Fasina, F.O. Antimicrobial Use, Residues, Resistance and Governance in the Food and Agriculture Sectors, Tanzania. Antibiotics 2021, 10, 454. [Google Scholar] [CrossRef]
- Lekshmi, M.; Ammini, P.; Kumar, S.; Varela, M.F. The Food Production Environment and the Development of Antimicrobial Resistance in Human Pathogens of Animal Origin. Microorganisms 2017, 5, 11. [Google Scholar] [CrossRef]
- de Mesquita Souza Saraiva, M.; Lim, K.; do Monte, D.F.M.; Givisiez, P.E.N.; Alves, L.B.R.; de Freitas Neto, O.C.; Kariuki, S.; Júnior, A.B.; de Oliveira, C.J.B.; Gebreyes, W.A. Antimicrobial resistance in the globalized food chain: A One Health perspective applied to the poultry industry. Braz. J. Microbiol. Publ. Braz. Soc. Microbiol. 2022, 53, 465–486. [Google Scholar] [CrossRef]
- Khater, D.F.; Lela, R.A.; El-Diasty, M.; Moustafa, S.A.; Wareth, G. Detection of harmful foodborne pathogens in food samples at the points of sale by MALDT-TOF MS in Egypt. BMC Res. Notes 2021, 14, 112. [Google Scholar] [CrossRef] [PubMed]
- Ejaz, H.; Younas, S.; Abosalif, K.O.; Junaid, K.; Alzahrani, B.; Alsrhani, A.; Abdalla, A.E.; Ullah, M.I.; Qamar, M.U.; Hamam, S.S. Molecular analysis of bla SHV, bla TEM, and bla CTX-M in extended-spectrum β-lactamase producing Enterobacteriaceae recovered from fecal specimens of animals. PLoS ONE 2021, 16, e0245126. [Google Scholar] [CrossRef] [PubMed]
- Usman Qamar, M.; S Lopes, B.; Hassan, B.; Khurshid, M.; Shafique, M.; Atif Nisar, M.; Mohsin, M.; Nawaz, Z.; Muzammil, S.; Aslam, B. The present danger of New Delhi metallo-β-lactamase: A threat to public health. Future Microbiol. 2020, 15, 1759–1778. [Google Scholar] [CrossRef]
- Saleem, Z.; Godman, B.; Azhar, F.; Kalungia, A.C.; Fadare, J.; Opanga, S.; Markovic-Pekovic, V.; Hoxha, I.; Saeed, A.; Al-Gethamy, M. Progress on the national action plan of Pakistan on antimicrobial resistance (AMR): A narrative review and the implications. Expert Rev. Anti-Infect. Ther. 2022, 20, 71–93. [Google Scholar] [CrossRef]
- Ejaz, H.; Qamar, M.U.; Junaid, K.; Younas, S.; Taj, Z.; Bukhari, S.N.A.; Abdalla, A.E.; Abosalif, K.O.; Ahmad, N.; Saleem, Z. The Molecular Detection of Class B and Class D Carbapenemases in Clinical Strains of Acinetobacter calcoaceticus-baumannii Complex: The High Burden of Antibiotic Resistance and the Co-Existence of Carbapenemase Genes. Antibiotics 2022, 11, 1168. [Google Scholar] [CrossRef]
- WMA. Declaration of Helsinki—Ethical Principles for Medical Research Involving Human Subjects. Available online: https://www.wma.net/policies-post/wma-declaration-of-helsinki-ethical-principles-for-medical-research-involving-human-subjects/ (accessed on 4 January 2023).
- CLSI. Performance Standards for Antimicrobial Susceptibility Testing, 32nd ed.; Clinical and Laboratory Standard Institute (CLSI): Wayne, PA USA, 2022; Volume CLSI supplement M100. [Google Scholar]
- Javed, H.; Saleem, S.; Zafar, A.; Ghafoor, A.; Shahzad, A.B.; Ejaz, H.; Junaid, K.; Jahan, S. Emergence of plasmid-mediated mcr genes from Gram-negative bacteria at the human-animal interface. Gut. Pathog. 2020, 12, 54. [Google Scholar] [CrossRef] [PubMed]
- Qamar, M.U.; Walsh, T.R.; Toleman, M.A.; Tyrrell, J.M.; Saleem, S.; Aboklaish, A.; Jahan, S. Dissemination of genetically diverse NDM-1,-5,-7 producing-Gram-negative pathogens isolated from pediatric patients in Pakistan. Future Microbiol. 2019, 14, 691–704. [Google Scholar] [CrossRef]
- Qamar, M.U.; Saleem, S.; Arshad, U.; Rasheed, M.F.; Ejaz, H.; Shahzad, N.; Shah, J. Antibacterial efficacy of Manuka honey against New Delhi Metallo-β-Lactamase producing Gram negative bacteria isolated from blood cultures. Pak. J. Zool. 2017, 49, 1997–2003. [Google Scholar] [CrossRef]
- Qamar, M.U.; Saleem, S.; Toleman, M.A.; Saqalein, M.; Waseem, M.; Nisar, M.A.; Khurshid, M.; Taj, Z.; Jahan, S. In vitro and in vivo activity of Manuka honey against NDM-1-producing Klebsiella pneumoniae ST11. Future Microbiol. 2018, 13, 13–26. [Google Scholar] [CrossRef]
- Ejaz, H.; Younas, S.; Qamar, M.U.; Junaid, K.; Abdalla, A.E.; Abosalif, K.O.A.; Alameen, A.A.M.; Elamir, M.Y.M.; Ahmad, N.; Hamam, S.S.M.; et al. Molecular Epidemiology of Extensively Drug-Resistant mcr Encoded Colistin-Resistant Bacterial Strains Co-Expressing Multifarious β-Lactamases. Antibiotics 2021, 10, 467. [Google Scholar] [CrossRef]
- Fung, F.; Wang, H.-S.; Menon, S. Food safety in the 21st century. Biomed. J. 2018, 41, 88–95. [Google Scholar] [CrossRef]
- Rortana, C.; Nguyen-Viet, H.; Tum, S.; Unger, F.; Boqvist, S.; Dang-Xuan, S.; Koam, S.; Grace, D.; Osbjer, K.; Heng, T.; et al. Prevalence of Salmonella spp. and Staphylococcus aureus in Chicken Meat and Pork from Cambodian Markets. Pathogens 2021, 10, 556. [Google Scholar] [CrossRef]
- Ilyas, S.; Qamar, M.U.; Rasool, M.H.; Abdulhaq, N.; Nawaz, Z. Multidrug-resistant pathogens isolated from ready-to-eat salads available at a local market in Pakistan. Br. Food J. 2016, 118, 2068–2075. [Google Scholar] [CrossRef]
- Berhe, G.; Wasihun, A.G.; Kassaye, E.; Gebreselasie, K. Milk-borne bacterial health hazards in milk produced for commercial purpose in Tigray, northern Ethiopia. BMC Public Health 2020, 20, 894. [Google Scholar] [CrossRef]
- Mohsin, M.; Van Boeckel, T.P.; Saleemi, M.K.; Umair, M.; Naseem, M.N.; He, C.; Khan, A.; Laxminarayan, R. Excessive use of medically important antimicrobials in food animals in Pakistan: A five-year surveillance survey. Glob. Health Action 2019, 12, 1697541. [Google Scholar] [CrossRef] [PubMed]
- Zhang, Y.; Lu, J.; Yan, Y.; Liu, J.; Wang, M. Antibiotic residues in cattle and sheep meat and human exposure assessment in southern Xinjiang, China. Food Sci. Nutr. 2021, 9, 6152–6161. [Google Scholar] [CrossRef] [PubMed]
- Siddique, A.; Azim, S.; Ali, A.; Andleeb, S.; Ahsan, A.; Imran, M.; Rahman, A. Antimicrobial Resistance Profiling of Biofilm Forming Non Typhoidal Salmonella enterica Isolates from Poultry and Its Associated Food Products from Pakistan. Antibiotics 2021, 10, 785. [Google Scholar] [CrossRef] [PubMed]
- Rybak, B.; Potrykus, M.; Plenis, A.; Wolska, L. Raw Meat Contaminated with Cephalosporin-Resistant Enterobacterales as a Potential Source of Human Home Exposure to Multidrug-Resistant Bacteria. Molecules 2022, 27, 4151. [Google Scholar] [CrossRef] [PubMed]
- Kakati, S.; Talukdar, A.; Hazarika, R.A.; Raquib, M.; Laskar, S.K.; Saikia, G.K.; Hussein, Z. Bacteriological quality of raw milk marketed in and around Guwahati city, Assam, India. Vet. World 2021, 14, 656–660. [Google Scholar] [CrossRef] [PubMed]
- Jahantigh, M.; Samadi, K.; Dizaji, R.E.; Salari, S. Antimicrobial resistance and prevalence of tetracycline resistance genes in Escherichia coli isolated from lesions of colibacillosis in broiler chickens in Sistan, Iran. BMC Vet. Res. 2020, 16, 267. [Google Scholar] [CrossRef] [PubMed]
- Bahmani, K.; Shahbazi, Y.; Nikousefat, Z. Monitoring and risk assessment of tetracycline residues in foods of animal origin. Food Sci. Biotechnol. 2020, 29, 441–448. [Google Scholar] [CrossRef] [PubMed]
- Kabrite, S.; Bou-Mitri, C.; Fares, J.E.H.; Hassan, H.F.; Boumosleh, J.M. Identification and dietary exposure assessment of tetracycline and penicillin residues in fluid milk, yogurt, and labneh: A cross-sectional study in Lebanon. Vet. World 2019, 12, 527–534. [Google Scholar] [CrossRef]
- Ulomi, W.J.; Mgaya, F.X.; Kimera, Z.; Matee, M.I. Determination of Sulphonamides and Tetracycline Residues in Liver Tissues of Broiler Chicken Sold in Kinondoni and Ilala Municipalities, Dar es Salaam, Tanzania. Antibiotics 2022, 11, 1222. [Google Scholar] [CrossRef] [PubMed]
- Treiber, F.M.; Beranek-Knauer, H. Antimicrobial Residues in Food from Animal Origin—A Review of the Literature Focusing on Products Collected in Stores and Markets Worldwide. Antibiotics 2021, 10, 534. [Google Scholar] [CrossRef]

| Gene | Primer (5′ to 3′) | Annealing Temperature |
|---|---|---|
| blaCTX-M-F | ATGTGCAGYACCAGTAARGTKATGGC | 62 °C |
| blaCTX-M-R | TGGGTRAARTARGTSACCAGAAYCAGCGG | |
| blaTEM-F | CGCCGCATACACTATTCTCAGAATGA | 62 °C |
| blaTEM-R | ACGCTCACCGGCTCCAGATTTAT | |
| blaNDM-1-F | ATGGAATTGCCCAATATTATGCAC | 58 °C |
| blaNDM-1-R | TCAGCGCAGCTTGTCGGC | |
| blaOXA-51-F | TAATGCTTTGATCGGCCTTG | 52 °C |
| blaOXA-51-R | TGGATTGCACTTCATCTTGG | |
| blaOXA-23-F | GATCGGATTGGAGAACCAGA | 52 °C |
| blaOXA-23-R | ATTTCTGACCGCATTTCCAT | |
| blaOXA-24-F | GGTTAGTTGGCCCCCTTAAA | 52 °C |
| blaOXA-24-R | AGT TGAGCGAAAAGGGGATT | |
| mecA-F | AAAATCGATGGTAAAGGTTGGC | 53 °C |
| mecA-R | AGTTCTGGAGTACCGGATTTGC | |
| tet-F | GGCCTCAATTTCCTGACG | 59 °C |
| tet-R | AAGCAGGATGTAGCCTGTGC |
| Source of Sample | Beef Sample | Isolate | Milk Sample | Isolate |
|---|---|---|---|---|
| Jinnah Colony | B-1 | S. aureus | M-1 | E. coli |
| E. coli | Pseudomonas aeruginosa | |||
| B-2 | E. coli | M-2 | E. coli | |
| B-3 | Proteus mirabilis | M-3 | K. pneumoniae | |
| E. coli | M-4 | K. pneumoniae | ||
| B-4 | Salmonella spp. | P. aeruginosa | ||
| E. coli | M-5 | E. coli | ||
| B-5 | K. pneumoniae | Salmonella spp. | ||
| B-6 | E. coli | M-6 | S. aureus | |
| B-7 | E. coli | P. aeruginosa | ||
| K. pneumoniae | M-7 | K. pneumoniae | ||
| B-8 | E. coli | Enterococcus faecalis | ||
| B-9 | E. coli | M-8 | S. aureus | |
| Muslim Colony | B-10 | E. coli | E. coli | |
| P. mirabilis | M-9 | S. aureus | ||
| B-11 | K. pneumoniae | Serratia marcescens | ||
| B-12 | P. mirabilis | M-10 | K. pneumoniae | |
| E. coli | E. coli | |||
| B-13 | E. coli | M-11 | Enterobacter cloacae | |
| K. pneumoniae | E. coli | |||
| B-14 | S. aureus | M-12 | Acinetobacter baumannii | |
| E. coli | E. coli | |||
| B-15 | E. coli | M-13 | S. aureus | |
| S. aureus | E. coli | |||
| B-16 | Salmonella spp. | M-14 | S. aureus | |
| E. coli | E. coli | |||
| B-17 | S. aureus | M-15 | A. baumannii | |
| E. coli | E. coli | |||
| B-18 | S. aureus | M-16 | S. aureus | |
| E. coli | S. marcescens | |||
| Samanabad Colony | B-19 | E. coli | M-17 | P. aeruginosa |
| K. pneumoniae | E. coli | |||
| B-20 | E. coli | M-18 | A. baumannii | |
| A. baumannii | E. coli | |||
| B-21 | E. coli | M-19 | E. faecalis | |
| B-22 | K. pneumoniae | K. pneumoniae | ||
| Salmonella spp. | M-20 | E. coli | ||
| B-23 | A. baumannii | M-21 | E. coli | |
| E. coli | M-22 | E. cloacae | ||
| B-24 | K. pneumoniae | S. marcescens | ||
| B-25 | E. coli | M-23 | K. pneumoniae | |
| A. baumannii | S. aureus | |||
| B-26 | Salmonella spp. | M-24 | Salmonella spp. | |
| B-27 | E. coli | E. coli | ||
| People’s Colony | P. aeruginosa | M-25 | E. coli | |
| B-28 | E. cloacae | P. aeruginosa | ||
| K. pneumoniae | M-26 | A. baumannii | ||
| B-29 | E. coli | P. aeruginosa | ||
| B-30 | E. coli | M-27 | E. faecalis | |
| E. cloacae | E. coli | |||
| B-31 | K. pneumoniae | M-28 | E. coli | |
| E. cloacae | K. pneumoniae | |||
| B-32 | Salmonella spp. | M-29 | K. pneumoniae | |
| B-33 | E. coli | M-30 | Citrobacter freundii | |
| B-34 | K. pneumoniae | K. pneumoniae | ||
| E. coli | M-31 | P. aeruginosa | ||
| B-35 | P. aeruginosa | S. aureus | ||
| B-36 | E. coli | M-32 | A. baumannii | |
| Shadab Colony | Salmonella spp. | M-33 | K. pneumoniae | |
| B-37 | K. pneumoniae | S. aureus | ||
| B-38 | S. aureus | M-34 | S. marcescens | |
| E. coli | E. coli | |||
| B-39 | E. coli | M-35 | P. aeruginosa | |
| Salmonella spp. | M-36 | S. marcescens | ||
| B-40 | P. aeruginosa | S. aureus | ||
| - | - | M-37 | E. coli | |
| - | - | P. aeruginosa | ||
| - | - | M-38 | E. coli | |
| - | - | Salmonella spp. | ||
| - | - | M-39 | S. marcescens | |
| - | - | K. pneumoniae | ||
| - | - | M-40 | E. coli | |
| - | - | K. pneumoniae |
| Isolates from Beef | AMP (≥32) | CRO (≥4) | FEP (≥16) | AMC (≥32/16) | CIP (≥4) | OFX (≥2) | TET (≥16) | TOB (≥16) | AK (≥64) | CN (≥16) | SXT (≥4/76) | IMP (≥4) | MEM (≥4) | CS (≥4) | P (≥0.25) | E (≥8) | FOX (≥8) | DA (≥4) | VA (≥16) |
|---|---|---|---|---|---|---|---|---|---|---|---|---|---|---|---|---|---|---|---|
| WHO classification | Access | Watch | Watch | Access | Watch | Watch | Watch | Watch | Access | Access | Access | Watch | Watch | Reserve | Access | Watch | Watch | Access | Watch |
| Escherichia coli (n = 29) | 100% | 44.8%s | 33.0% | 79.3% | 44.8% | 51.7% | 58.6% | 44.8% | 20.8% | 62% | 55.1% | 24.1% | 20.6%% | 0% | NT | NT | NT | NT | NT |
| Klebsiella pneumoniae (n = 11) | NT | 72.70% | 72.7% | 72.7% | 45.5% | 36.3% | 90.9% | 72.7% | 27.2% | 90.9% | 63.6% | 18.1% | 18.1% | 0% | NT | NT | NT | NT | NT |
| Salmonella spp. (n = 7) | 100% | 0% | 0% | 28.5% | 0% | 14.2% | 28.7% | 28.7% | 0% | 57.1% | 85.7% | 0% | 0% | NT | NT | NT | NT | NT | NT |
| Acinetobacter baumannii (n = 3) | 100% | 33.3% | 33.3% | 33.3% | 33.3% | 33.3% | 100% | 33.3% | 33.3% | 100% | 66.6% | 0% | 0% | 0% | NT | NT | NT | NT | NT |
| Enterobacter cloacae (n = 3) | 100% | 66.6% | 66.6% | 66.6% | 66.6% | 33.3% | 66.6% | 100% | 33.3% | 100% | 100% | 33.3% | 33.3% | 0% | NT | NT | NT | NT | NT |
| Pseudomonas aeruginosa (n = 3) | 100% | 66.6% | 66.6% | 100% | 66.6% | 66.6% | 100% | 33.3% | 0% | 33.3% | 100% | 33.3% | 33.3% | 0% | NT | NT | NT | NT | NT |
| Proteus mirabilis (n = 3) | 100% | 0% | 0% | 100% | 33.3% | 33.3% | 33.3% | 33.3% | 0% | 33.3% | 33.3% | 0% | 0% | 100% | NT | NT | NT | NT | NT |
| Staphylococcus aureus (n = 6) | NT | 50% | 50% | 100% | 50% | 50% | 33.3% | 16.6% | 0% | 16.6% | 50% | 50% | 50% | NT | 100% | 83.3% | 50% | 33.3% | 0% |
| Milk Isolates | AMP (≥32) | CRO (≥4) | FEP (≥16) | AMC (≥32/16) | CIP (≥4) | OFX (≥2) | TET (≥16) | TOB (≥16) | AK (≥64) | CN (≥16) | SXT (≥4/76) | IMP (≥4) | MEM (≥4) | CS (≥4) | P (≥0.25) | E (≥8) | FOX (≥8) | DA (≥4) | VA (≥16) |
|---|---|---|---|---|---|---|---|---|---|---|---|---|---|---|---|---|---|---|---|
| WHO classification | Access | Watch | Watch | Access | Watch | Watch | Watch | Watch | Access | Access | Access | Watch | Watch | Reserve | Access | Watch | Watch | Access | Watch |
| Escherichia coli (n = 22) | 100% | 63.6% | 63.6% | 77.20% | 68.1% | 68.1% | 63.6% | 54.5% | 18.1% | 90.9% | 59% | 13.6% | 13.6% | 0% | NT | NT | NT | NT | NT |
| Klebsiella pneumoniae (n = 12) | NT | 41.6% | 41.6% | 75% | 50% | 50% | 58.3% | 25% | 16.6% | 83.3 % | 66.6% | 0% | 0% | 0% | NT | NT | NT | NT | NT |
| Pseudomonas aeruginosa (n = 9) | 100% | 33.3% | 33.3% | 77.6% | 77.6% | 77.7% | 44.4% | 44.4% | 11.10% | 88.8% | 66.6% | 0% | 0% | 0% | NT | NT | NT | NT | NT |
| Serratia marcescens (n = 6) | 100% | 50% | 66.6% | 66.6% | 33.3% | 33.3% | 66.6% | 50% | 16.6% | 83.30% | 66.6% | 0% | 0% | 0% | NT | NT | NT | NT | NT |
| Acinetobacter baumannii (n = 5) | 100% | 60% | 60% | 60% | 40% | 40% | 60% | 60% | 20% | 80% | 80% | 0% | 0% | 0% | NT | NT | NT | NT | NT |
| Salmonella spp. (n = 3) | 100% | 0% | 0% | 0% | 33.3% | 33.3% | 0% | 0% | 0% | 33.3% | 66.6% | 0% | 0% | 0% | NT | NT | NT | NT | NT |
| Enterobacter cloacae (n = 2) | 100% | 100% | 50% | 100% | 50% | 50% | 50% | 50% | 0% | 50% | 50% | 0% | 0% | 0% | NT | NT | NT | NT | NT |
| Citrobacter freundii (n = 1) | 100% | 0% | 0% | 100% | 0% | 0% | 0% | 0% | 0% | 100% | 0% | 0% | 0% | 0% | 100% | 83.3% | 50% | 33.3% | 0% |
| Staphylococcus aureus (n = 10) | NT | 30% | 30% | 70% | 30% | 30% | 50% | 60% | 0% | 40% | 50% | 30% | 30% | NT | 100% | 70% | 30% | 40% | 0% |
| Enterococcus faecalis (n = 3) | 100% | 100% | 100% | 100% | 33.30% | 33,3% | 0% | 100% | 66.6% | 100% | 66.6% | 0% | 0% | NT | NT | 66.6% | 100% | 66.6% | 0% |
| Beef Sample | TET AR (ppb) | MRL (ppb) | TET Antibiotic | tet Gene | Milk Sample | TET AR (ppb) | TET Antibiotic | MRL (ppb) | tet Gene |
|---|---|---|---|---|---|---|---|---|---|
| B-1 | 162 | 100 | R | Post | M-1 | 4 | S | 100 | Neg |
| B-2 | 130 | 100 | R | Post | M-2 | 170 | R | 100 | Post |
| B-3 | 175 | 100 | R | Post | M-3 | 17 | S | 100 | Neg |
| B-4 | 110 | 100 | R | Neg | M -4 | 3 | S | 100 | Neg |
| B-5 | 115 | 100 | R | Post | M-5 | 101 | S | 100 | Neg |
| B-6 | 19 | 100 | S | Neg | M-6 | 11 | S | 100 | Neg |
| B-7 | 174 | 100 | R | Post | M-7 | 127 | R | 100 | Neg |
| B-8 | 15 | 100 | S | Neg | M-8 | 6 | S | 100 | Neg |
| B-9 | 156 | 100 | R | Post | M-9 | 129 | R | 100 | Neg |
| B-10 | 6 | 100 | S | Neg | M-10 | 197 | R | 100 | Post |
| B-11 | 112 | 100 | R | Post | M-11 | 201 | R | 100 | Post |
| B-12 | 17 | 100 | S | Neg | M-12 | 220 | R | 100 | Post |
| B-13 | 111 | 100 | R | Post | M-13 | 135 | S | 100 | Post |
| B-14 | 24 | 100 | S | Neg | M-14 | 55 | S | 100 | Neg |
| B-15 | 13 | 100 | S | Neg | M-15 | 167 | R | 100 | Neg |
| B-16 | 198 | 100 | S | Neg | M-16 | 7 | S | 100 | Neg |
| B-17 | 125 | 100 | R | Neg | M-17 | 180 | R | 100 | Neg |
| B-18 | 15 | 100 | S | Neg | M-18 | 133 | R | 100 | Post |
| B-19 | 180 | 100 | R | Post | M-19 | 186 | R | 100 | Post |
| B-20 | 18 | 100 | R | Post | M-20 | 7 | S | 100 | Neg |
| B-21 | 197 | 100 | R | Post | M-21 | 122 | R | 100 | Post |
| B-22 | 20 | 100 | S | Neg | M-22 | 11 | S | 100 | Neg |
| B-23 | 211 | 100 | R | Post | M-23 | 13 | S | 100 | Neg |
| B-24 | 174 | 100 | R | Neg | M-24 | 5 | S | 100 | Neg |
| B-25 | 20 | 100 | S | Neg | M-25 | 164 | R | 100 | Post |
| B-26 | 117 | 100 | R | Neg | M-26 | 18 | S | 100 | Neg |
| B-27 | 213 | 100 | R | Post | M-27 | 143 | R | 100 | Post |
| B-28 | 25 | 100 | S | Neg | M-28 | 10 | S | 100 | Neg |
| B-29 | 4 | 100 | S | Neg | M-29 | 178 | R | 100 | Post |
| B-30 | 135 | 100 | R | Post | M-30 | 16 | S | 100 | Neg |
| B-31 | 26 | 100 | R | Neg | M-31 | 111 | R | 100 | Post |
| B-32 | 28 | 100 | S | Neg | M-32 | 8 | S | 100 | Neg |
| B-33 | 24 | 100 | S | Neg | M-33 | 186 | R | 100 | Post |
| B-34 | 201 | 100 | R | Post | M-34 | 110 | R | 100 | Post |
| B-35 | 189 | 100 | R | Post | M-35 | 21 | S | 100 | Neg |
| B-36 | 30 | 100 | S | Neg | M-36 | 16 | S | 100 | Neg |
| B-37 | 35 | 100 | R | Neg | M-37 | 112 | R | 100 | Post |
| B-38 | 6 | 100 | S | Neg | M-38 | 140 | R | 100 | Post |
| B-39 | 140 | 100 | R | Post | M-39 | 14 | R | 100 | Post |
| B-40 | 177 | 100 | R | Post | M-40 | 110 | R | 100 | Post |
Disclaimer/Publisher’s Note: The statements, opinions and data contained in all publications are solely those of the individual author(s) and contributor(s) and not of MDPI and/or the editor(s). MDPI and/or the editor(s) disclaim responsibility for any injury to people or property resulting from any ideas, methods, instructions or products referred to in the content. |
© 2023 by the authors. Licensee MDPI, Basel, Switzerland. This article is an open access article distributed under the terms and conditions of the Creative Commons Attribution (CC BY) license (https://creativecommons.org/licenses/by/4.0/).
Share and Cite
Qamar, M.U.; Aatika; Chughtai, M.I.; Ejaz, H.; Mazhari, B.B.Z.; Maqbool, U.; Alanazi, A.; Alruwaili, Y.; Junaid, K. Antibiotic-Resistant Bacteria, Antimicrobial Resistance Genes, and Antibiotic Residue in Food from Animal Sources: One Health Food Safety Concern. Microorganisms 2023, 11, 161. https://doi.org/10.3390/microorganisms11010161
Qamar MU, Aatika, Chughtai MI, Ejaz H, Mazhari BBZ, Maqbool U, Alanazi A, Alruwaili Y, Junaid K. Antibiotic-Resistant Bacteria, Antimicrobial Resistance Genes, and Antibiotic Residue in Food from Animal Sources: One Health Food Safety Concern. Microorganisms. 2023; 11(1):161. https://doi.org/10.3390/microorganisms11010161
Chicago/Turabian StyleQamar, Muhammad Usman, Aatika, Muhammad Ismail Chughtai, Hasan Ejaz, Bi Bi Zainab Mazhari, Uzma Maqbool, Awadh Alanazi, Yasir Alruwaili, and Kashaf Junaid. 2023. "Antibiotic-Resistant Bacteria, Antimicrobial Resistance Genes, and Antibiotic Residue in Food from Animal Sources: One Health Food Safety Concern" Microorganisms 11, no. 1: 161. https://doi.org/10.3390/microorganisms11010161
APA StyleQamar, M. U., Aatika, Chughtai, M. I., Ejaz, H., Mazhari, B. B. Z., Maqbool, U., Alanazi, A., Alruwaili, Y., & Junaid, K. (2023). Antibiotic-Resistant Bacteria, Antimicrobial Resistance Genes, and Antibiotic Residue in Food from Animal Sources: One Health Food Safety Concern. Microorganisms, 11(1), 161. https://doi.org/10.3390/microorganisms11010161

